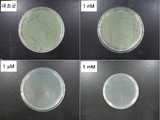

본원은 항균 조성물 및 상기 항균 조성물을 이용한 표면 항균처리 방법에 관한 것이다.The present invention relates to an antimicrobial composition and a surface antibacterial treatment method using the antimicrobial composition.
최근, 건강에 대한 관심이 높아짐에 따라, 섬유, 휴대용 전자기기, 건축재료, 가전제품, 필터, 포장용 자재, 식품 제조 설비, 약품 제조 설비, 의료 설비 등 다양한 분야에서, 항균성을 갖는 조성물, 소위 항균 조성물이 널리 이용되고 있다. 원래 항균제는 세균을 죽이는 것보다 세균의 증식을 억제하여 세균이 자랄 수 없는 어려운 환경을 만드는 것을 목적으로 하고 있다. 이러한 항균 조성물에 함유되는 항균제는, 안전성이 우수하고 항균작용이 장시간 유지되며, 내열성도 우수해야 한다.2. Description of the Related Art Recently, interest in health has increased, and a composition having antimicrobial activity in a variety of fields such as fibers, portable electronic devices, building materials, household appliances, filters, packaging materials, food manufacturing facilities, Compositions have been widely used. Originally, antimicrobial agents are intended to inhibit bacterial growth rather than kill germs, creating a difficult environment in which bacteria can not grow. The antimicrobial agent contained in such an antimicrobial composition should have excellent safety, maintain antimicrobial action for a long time, and be excellent in heat resistance.
항균제는 크게 나누어 유기계 항균제와 무기계 항균제의 두 가지로 나누어지며, 그 특성상 용출 타입과 접촉 타입으로 분류되는데, 일반적으로 용출 타입은 주로 항균물질을 서서히 용출시키는 방법으로 독성을 가지는 유기항균제나 금속이온을 용출시킨다.Antimicrobial agents are generally divided into two types, organic-based and inorganic-based. Antimicrobial agents are classified into two types: organic-based and inorganic-based. .
시중에서 항균제로서 흔히 이용되는 금속 물질로는 은 (예를 들어, 질산은, 은 설파디아진 등)이 있는데, 은은 박테리아 내성을 최소한으로 발현시키는 특성을 가지므로, 은 또는 은 화합물을 포함하는 항균 조성물이 다양한 용도로 이용되고 있다. 예를 들어, 미국 특허 제2,791,518호 (Stokes et al.)에는 질산은 및 질산바륨 등을 이용하여 항균 제품을 제조하는 방법이 기재되어 있다. 그러나 이러한 금속류 항균제는 섬유에 입힐 경우 접착력에 문제가 있어서 제올라이트나 인산 티타늄 화합물 등의 형태로 섬유나 고분자 표면에 도포하기도 하는데, 그 접착특성에 한계가 있을 수밖에 없다. 또한, 이들 원료가 고가일 뿐만 아니라, 일반적으로 빛에 안정적이지 않고 접촉 시 피부에 얼룩을 남기며, 장시간 사용 시 소모되는 문제점이 있다. 아울러, 유기 항균제는 용출 속도를 조절하기 어렵고 용출된 유기 항균제의 인체에 대한 독성 유무로 인하여 사용이 많이 제한되고 가격 또한 비싸다. 종합해 보건대 아직까지 항균특성을 가지는 물질의 개발이 더디며 더 나아가 이들 항균물질들을 섬유나 필름 등에 활용하는 방법이 제대로 개발되고 있지 못하다.Silver (for example, silver nitrate, silver sulfadiazine, etc.) is commonly used as a metal material that is commonly used as an antimicrobial agent in the market. Since silver has a characteristic of minimizing bacterial resistance, an antimicrobial composition Are used for various purposes. For example, U.S. Patent No. 2,791,518 (Stokes et al.) Describes a method for producing an antibacterial product using silver nitrate and barium nitrate. However, these metal antimicrobial agents have problems in adhesion when they are applied to fibers, so they may be applied on the surface of fibers or polymers in the form of zeolite or titanium phosphate compound. However, their adhesive properties are limited. In addition, these raw materials are not only expensive, they are not stable to light in general, leave a spot on the skin when they are in contact, and are consumed when they are used for a long time. In addition, the organic antimicrobial agent is difficult to control the elution rate and the use of the eluted organic antimicrobial agent is limited because of toxicity to the human body and the price is also high. In addition, the development of materials with antibacterial properties has been slow, and methods for using these antibacterial materials in fibers and films have not been developed properly.
한편, 바이올로겐 (viologen)계 화합물은 그의 산화-환원 성질로 인하여, 전지전극, 트랜지스터 등의 소재 개발에 있어서 전자전달 매개체로서 많이 이용되고 있는 물질이다. 이러한 산화환원 특성을 활용하여 메틸바이올로겐 (1,1'-dimethyl-4,4'-bipyridylium)이라는 화합물은 식물의 성장에 관여하는 것이 알려져 있고 Paraquat이라는 상품명의 제초제로서 대규모로 사용되고 있다 [Environmental Health Perspectives, 1984, Vol. 55, pp. 37-46]. 이러한 바이올로겐계 화합물들은 제초제로서 다양한 특성을 보여주었지만 미생물 생장 저해에 관한 항균성에 대하여는 제대로 보고된 바가 없으며, 특히 섬유나 고분자 표면에 표면 항균 처리제로서 개발 보고된 바가 없다. 통상 바이올로겐계 화합물은 알킬기, 특히 메틸기를 가지는 메틸바이올로겐이 주로 사용되며 탄소수가 2 이상인 치환기를 가지는 바이올로겐계 화합물도 사용되고 있으나 그 특성에서는 큰 차이를 주지 못하고 있다. 또한, 알킬바이올로겐이 산화환원의 물리적 특성을 가지는 반면에 화학적 반응성은 거의 없기 때문에 알킬바이올로겐을 이용한 반응이나 표면 처리 등은 가능하지 않은 실정이다.On the other hand, viologen-based compounds are widely used as electron transfer mediators in the development of materials for cell electrodes and transistors due to their oxidation-reduction properties. Using such redox properties, compounds called 1,1'-dimethyl-4,4'-bipyridylium are known to be involved in plant growth and are being used on a large scale as herbicides of the trade name Paraquat [Environmental Health Perspectives, 1984, Vol. 55, pp. 37-46]. Although these viologen compounds have shown various properties as herbicides, there has been no report on antimicrobial activity against the inhibition of growth of microorganisms. Especially, development of surface antimicrobial agents on the surface of fibers and polymers has not been reported. Generally, the viologen-based compound is an alkyl group, especially a methyl viologen having a methyl group, and a viologen-based compound having a substituent having a carbon number of 2 or more is also used, but the characteristics are not greatly different. In addition, while alkylbenzogens have physical properties of redox reaction, there is almost no chemical reactivity. Therefore, reaction with alkyl biogens or surface treatment is not possible.
이에, 본원은 항균 조성물 및 상기 항균 조성물을 이용한 표면 항균처리 방법을 제공하고자 한다.Accordingly, the present invention provides an antimicrobial composition and a surface antibacterial treatment method using the antimicrobial composition.
그러나, 본원이 해결하고자 하는 과제는 이상에서 언급한 과제로 제한되지 않으며, 언급되지 않은 또 다른 과제들은 아래의 기재로부터 당업자에게 명확하게 이해될 수 있을 것이다.However, the problems to be solved by the present invention are not limited to the above-mentioned problems, and other problems not mentioned can be clearly understood by those skilled in the art from the following description.
본원의 제 1 측면은, 하기 화학식 1로서 표시되는 알킬-바이올로겐 유도체 화합물을 포함하는, 항균 조성물을 제공한다:A first aspect of the invention provides an antimicrobial composition comprising an alkyl-viologen derivative compound represented by formula 1:
[화학식 1][Chemical Formula 1]
; ;
화학식 1에서, R1 및 R2는, 각각 독립적으로, X1 및 X2에 의해 각각 치환된 C1-10 선형 또는 분지형 알킬기를 포함하는 것이고, X1 및 X2는, 각각 독립적으로, -NH2, -NR3H, -NR3R4, -COOH, -SO3H, -SO2H, 및 -PR3R4로 이루어진 군으로부터 선택되는 것을 포함하며, 여기서 R3 및R4는 각각 독립적으로 C1-10 알킬기임.In
본원의 제 2 측면은, 상기 화학식 1로서 표시되는 알킬-바이올로겐 유도체 화합물을 포함하는 상기 항균 조성물을 기재에 도포하는 것을 포함하는, 표면 항균처리 방법을 제공한다.The second aspect of the present invention provides a surface antimicrobial treatment method comprising applying the antimicrobial composition comprising an alkyl-viologen derivative compound represented by the above formula (1) to a substrate.
본원에 의하면, 항균 성능이 우수한, 알킬-바이올로겐 유도체 화합물을 포함하는 항균 조성물 및 도포용 조성물을 제조할 수 있다. 본원에 따른 도포용 조성물은 섬유, 플라스틱, 종이, 유리, 고분자 필름, 금속 필름 등 다양한 기재에 적용시킬 수 있고, 도포 방법이 간단하기 때문에 다양한 분야에서 이용될 수 있다.According to the present invention, an antimicrobial composition and an application composition containing an alkyl-viologen derivative compound having excellent antibacterial performance can be produced. The composition for coating according to the present invention can be applied to various substrates such as fibers, plastics, paper, glass, polymer films, metal films, etc., and can be used in various fields because of its simple application method.
특히, 본원에 따르면, 바이올로겐의 산화환원 특성과 폴리아민의 생리활성 특성을 한 분자 내에 조합하여 바이올로겐의 특성과 아주 다른, 그리고 폴리아민과의 특성 또한 아주 다른, 새로운 개념의 항균 조성물을 제조할 수 있다. 본원에 따른 알킬-바이올로겐 유도체 화합물들은 탁월한 항균효과를 보일 뿐 아니라 균주를 사멸시키는 활성도 함께 보유한다.In particular, according to the present invention, a novel concept of an antimicrobial composition is produced by combining the redox properties of the biologen and the physiological activities of the polyamines in one molecule, which is very different from the characteristics of the viologen and also with the characteristics of polyamines can do. The alkyl-violgen derivative compounds according to the present invention not only have excellent antimicrobial activity but also have an activity of killing the strain.
도 1은, 본원의 일 실시예에 따라 제조된 항균 조성물을 다양한 농도로 처리한 경우 균주의 생육이 억제됨을 비교하여 보여주는 사진이다.
도 2는, 본원의 일 실시예에 따라 제조된 항균 조성물을 균주에 다양한 농도로 처리한 경우 항균활성을 보여주는 사진이다.
도 3은, 본원의 일 실시예에 따라 제조된 항균 조성물을 균주에 다양한 농도로 처리한 경우 항균활성을 보이는 영역의 크기를 측정한 그래프이다.
도 4는, 본원의 일 실시예에 따라 제조된 항균 조성물의 항균활성과 메틸 바이올로겐의 항균활성을 비교하여 보여주는 사진이다.
도 5a는, 본원의 일 실시예에 따라 제조된 도포용 조성물의 황색 포도상구균에 대한 항균도를 나타내는 사진이다.
도 5b는, 본원의 일 실시예에 따라 제조된 도포용 조성물의 폐렴균에 대한 항균도를 나타내는 사진이다.
도 6a는, 본원의 일 실시예에 따라 제조된 도포용 조성물의 황색 포도상구균에 대한 항균도를 나타내는 사진이다.
도 6b는, 본원의 일 실시예에 따라 제조된 도포용 조성물의 폐렴균에 대한 항균도를 나타내는 사진이다.
도 7a는, 본원의 일 실시예에 따라 제조된 도포용 조성물의 황색 포도상구균에 대한 항균력을 나타내는 사진이다.
도 7b는, 본원의 일 실시예에 따라 제조된 도포용 조성물의 대장균에 대한 항균력을 나타내는 사진이다.FIG. 1 is a photograph showing a comparison of inhibition of the growth of a strain when the antimicrobial composition prepared according to one embodiment of the present invention is treated at various concentrations.
FIG. 2 is a photograph showing antimicrobial activity when the antimicrobial composition prepared according to one embodiment of the present invention is treated at various concentrations in a strain. FIG.
FIG. 3 is a graph illustrating the size of a region showing antimicrobial activity when the antimicrobial composition prepared according to one embodiment of the present invention is treated at various concentrations in a strain.
FIG. 4 is a photograph showing the antimicrobial activity of the antimicrobial composition prepared according to one embodiment of the present invention and the antimicrobial activity of methyl viologen.
FIG. 5A is a photograph showing antibacterial activity against Staphylococcus aureus in a coating composition prepared according to one embodiment of the present invention. FIG.
5B is a photograph showing antibacterial activity against pneumococcus in a coating composition prepared according to one embodiment of the present invention.
6A is a photograph showing antibacterial activity against Staphylococcus aureus in a coating composition prepared according to one embodiment of the present invention.
FIG. 6B is a photograph showing antibacterial activity against pneumococcus in a coating composition prepared according to one embodiment of the present invention. FIG.
7A is a photograph showing antibacterial activity against Staphylococcus aureus in a coating composition prepared according to one embodiment of the present invention.
FIG. 7B is a photograph showing the antibacterial activity against E. coli of the coating composition prepared according to one embodiment of the present invention. FIG.
이하, 첨부한 도면을 참조하여 본원이 속하는 기술 분야에서 통상의 지식을 가진 자가 용이하게 실시할 수 있도록 본원의 실시예를 상세히 설명한다. 그러나 본원은 여러 가지 상이한 형태로 구현될 수 있으며 여기에서 설명하는 실시예에 한정되지 않는다. 그리고 도면에서 본원을 명확하게 설명하기 위해서 설명과 관계없는 부분은 생략하였으며, 명세서 전체를 통하여 유사한 부분에 대해서는 유사한 도면 부호를 붙였다.Hereinafter, embodiments of the present invention will be described in detail with reference to the accompanying drawings so that those skilled in the art can easily carry out the present invention. It should be understood, however, that the present invention may be embodied in many different forms and should not be construed as limited to the embodiments set forth herein. In the drawings, the same reference numbers are used throughout the specification to refer to the same or like parts.
본원 명세서 전체에서, 어떤 부분이 다른 부분과 "연결"되어 있다고 할 때, 이는 "직접적으로 연결"되어 있는 경우뿐 아니라, 그 중간에 다른 소자를 사이에 두고 "전기적으로 연결"되어 있는 경우도 포함한다.Throughout this specification, when a part is referred to as being "connected" to another part, it is not limited to a case where it is "directly connected" but also includes the case where it is "electrically connected" do.
본원 명세서 전체에서, 어떤 부재가 다른 부재 "상에" 위치하고 있다고 할 때, 이는 어떤 부재가 다른 부재에 접해 있는 경우뿐 아니라 두 부재 사이에 또 다른 부재가 존재하는 경우도 포함한다.Throughout this specification, when a member is "on " another member, it includes not only when the member is in contact with the other member, but also when there is another member between the two members.
본원 명세서 전체에서, 어떤 부분이 어떤 구성 요소를 "포함"한다고 할 때, 이는 특별히 반대되는 기재가 없는 한 다른 구성 요소를 제외하는 것이 아니라 다른 구성 요소를 더 포함할 수 있는 것을 의미한다.Throughout this specification, when an element is referred to as "including " an element, it is understood that the element may include other elements as well, without departing from the other elements unless specifically stated otherwise.
본원 명세서 전체에서 사용되는 정도의 용어 "약", "실질적으로" 등은 언급된 의미에 고유한 제조 및 물질 허용오차가 제시될 때 그 수치에서 또는 그 수치에 근접한 의미로 사용되고, 본원의 이해를 돕기 위해 정확하거나 절대적인 수치가 언급된 개시 내용을 비양심적인 침해자가 부당하게 이용하는 것을 방지하기 위해 사용된다.The terms "about "," substantially ", etc. used to the extent that they are used throughout the specification are intended to be taken to mean the approximation of the manufacturing and material tolerances inherent in the stated sense, Accurate or absolute numbers are used to help prevent unauthorized exploitation by unauthorized intruders of the referenced disclosure.
본원 명세서 전체에서 사용되는 정도의 용어 "~(하는) 단계" 또는 "~의 단계"는 "~를 위한 단계"를 의미하지 않는다.The word " step (or step) "or" step "used to the extent that it is used throughout the specification does not mean" step for.
본원 명세서 전체에서, 마쿠시 형식의 표현에 포함된 "이들의 조합(들)"의 용어는 마쿠시 형식의 표현에 기재된 구성 요소들로 이루어진 군에서 선택되는 하나 이상의 혼합 또는 조합을 의미하는 것으로서, 상기 구성 요소들로 이루어진 군에서 선택되는 하나 이상을 포함하는 것을 의미한다.Throughout this specification, the term "combination (s) thereof " included in the expression of the machine form means a mixture or combination of one or more elements selected from the group consisting of the constituents described in the expression of the form of a marker, Quot; means at least one selected from the group consisting of the above-mentioned elements.
본원 명세서 전체에서, "A 및/또는 B"의 기재는, "A 또는 B, 또는 A 및 B"를 의미한다.Throughout this specification, the description of "A and / or B" means "A or B, or A and B".
본원 명세서 전체에서, 용어 "알킬기"는, 각각, 선형 또는 분지형의, 포화 또는 불포화 C1-20 또는 C1-10알킬기를 포함하는 것일 수 있으며, 예를 들어, 메틸, 에틸, 프로필, 부틸, 펜틸, 헥실, 헵실, 옥틸, 노닐, 데실, 운데실, 도데실, 트리데실, 테트라데실, 펜타데실, 헥사데실, 헵타데실, 옥타데실, 노나데실, 에이코사닐, 또는 이들의 가능한 모든 이성질체를 포함하는 것일 수 있으나, 이에 제한되지 않을 수 있다.
Throughout the present specification, the term "alkyl group" are, respectively, a linear or branched, it may be one that contains a saturated or unsaturated C1-20 or C1-10 alkyl, e.g., methyl, ethyl, propyl, butyl But are not limited to, pentyl, hexyl, heptyl, octyl, nonyl, decyl, undecyl, dodecyl, tridecyl, tetradecyl, pentadecyl, hexadecyl, heptadecyl, octadecyl, nonadecyl, eicosanyl, But is not limited thereto.
이하, 본원의 구현예를 상세히 설명하였으나, 본원이 이에 제한되지 않을 수 있다.
Hereinafter, embodiments of the present invention are described in detail, but the present invention is not limited thereto.
본원의 제 1 측면은, 하기 화학식 1로서 표시되는 알킬-바이올로겐 유도체 화합물을 포함하는, 항균 조성물을 제공한다:A first aspect of the invention provides an antimicrobial composition comprising an alkyl-viologen derivative compound represented by formula 1:
[화학식 1][Chemical Formula 1]
; ;
화학식 1에서,In formula (1)
R1 및 R2는, 각각 독립적으로, X1 및 X2에 의해 각각 치환된, 선형 또는 분지형의 C1-10 알킬기를 포함하는 것이고, X1 및 X2는, 각각 독립적으로, -NH2, -NR3H, -NR3R4, -COOH, -SO3H, -SO2H, 및 -PR3R4로 이루어진 군으로부터 선택되는 것을 포함하며, 여기서 R3 및R4는 각각 독립적으로 C1-10 알킬기임.R1 and R2 are, each independently, is to include a C1-10 alkyl groups each substituted, linear or branched, by a X1 and X2, X1 and X2 are, each independently, -NH2 , -NR3 H, -NR3 R4 , -COOH, -SO3 H, -SO2 H, and -PR3 R4 , wherein R3 and R4 are each independently being C1-10 alkyl.
본원에 따르면, 종래 제초제로서 주로 이용되고 있는 바이올로겐 유도체 화합물들 중에서도 치환된 알킬-바이올로겐 유도체 화합물이 항균제로서 적합할 뿐만 아니라, 균주의 단백질과 반응하여 균주를 사멸시키는 활성이 있고, 특히 알킬-바이올로겐기 양 말단 또는 일측 말단에 아민기를 배치함으로써 기존 알킬-바이올로겐이 가지는 산화환원 특성을 넘어서 새로운 항균 특성을 발현시킬 수 있다. 특히 양 말단에 아민기를 가지는 물질들은 특별한 생리활성 특성을 가지는데, 이는 폴리아민 (polyamines: PAs)이라 통칭하는 물질군에 속하는 폴리아민이 유기체의 성장과 사멸에 중요한 역할을 하기 때문이다. 폴리아민은 생체 내에 아주 넓게 분포되어 있어서 세포 내에서 전사 (transcription), RNA 변형 (modification), 단백질 합성 (translation), 멤브레인 안정화 (membrane stabilization), 셀 신호의 조절 (modulation of cell signaling) 등의 단계에 관여한다 [Proceedings of National Academy of Sciences: PNAS, 2013, vol 109, 6343-6347]. 본원에 따르면, 바이올로겐의 산화환원 특성과 폴리아민의 생리활성 특성을 한 분자 내에 조합하여 바이올로겐의 특성과 아주 다른, 그리고 폴리아민과의 특성 또한 아주 다른, 새로운 개념의 항균 조성물을 제조할 수 있다. 본원에 따른 알킬-바이올로겐 유도체 화합물들은 탁월한 항균효과를 보일 뿐 아니라 균주를 사멸시키는 활성도 함께 보유한다.According to the present invention, among the viologen derivative compounds mainly used as herbicidal agents, substituted alkyl-viologen derivative compounds are suitable as antimicrobial agents, and have an activity of reacting with the protein of the strain to kill the strain, By arranging amine groups at both ends of the alkyl-viologen group, new antimicrobial properties can be expressed beyond the redox properties of the existing alkyl-biologen. Particularly, substances having amine groups at both ends have special physiological activity properties because polyamines belonging to the group of substances called polyamines (PAs) play an important role in the growth and death of organisms. Polyamines are widely distributed in vivo, and they can be used in many processes such as transcription, RNA modification, translation, membrane stabilization, and modulation of cell signaling. [Proceedings of the National Academy of Sciences: PNAS, 2013, vol. 109, 6343-6347]. According to the present invention, a novel concept of an antimicrobial composition can be prepared by combining the redox properties of the biologen and the physiological activity properties of polyamines in one molecule, and the properties of the polyorganism are very different from those of the biologen have. The alkyl-violgen derivative compounds according to the present invention not only have excellent antimicrobial activity but also have an activity of killing the strain.
본원에 따른 알킬-바이올로겐 유도체 화합물들은 X1 및 X2에 의해 치환된 알킬기의 크기에 따라 약간의 항균성 차이가 있기는 하지만 크게 차이가 나지는 않는다. 본원의 항균 조성물은 통상 C1-10 알킬기를 가지는 알킬-바이올로겐 유도체 화합물이 포함될 수 있다. 아울러, 상기 C1-10 알킬기에 치환된 아민기 대신에 카르복실기, 설페이트기, 포스페이트기 등이 사용될 수 있으며, 특성상 아민기를 가진 바이올로겐 유도체 화합물보다 낮은 항균성을 보이지만 그래도 의미 있는 항균물질로 이용될 수 있다.Although the alkyl-viologen derivative compounds according to the present invention have slightly different antimicrobial properties depending on the sizes of the alkyl groups substituted by X1 and X2 , they do not differ greatly. The antimicrobial composition of the present application is an alkyl having a normal C1-10 alkyl group can be included in the Hagen derivatives Biology. In addition, a carboxyl group, a sulfate group, a phosphate group and the like can be used in place of the amine group substituted with the C1-10 alkyl group, and they exhibit lower antimicrobial activity than the viologen derivative compound having an amine group by its nature. .
본원의 일 구현예에 있어서, 상기 알킬-바이올로겐 유도체 화합물은 +2의 양전하를 띠고 있는 물질로서, 하나 이상의 다양한 음이온들과 결합하여 착화합물을 형성할 수 있으나, 이에 제한되지 않을 수 있다. 이때, 상기 음이온은 특별히 제한되지 않는다.In one embodiment of the invention, the alkyl-violgen derivative compound is a substance having a positive charge of +2, and may form a complex with one or more various anions to form a complex, but may not be limited thereto. At this time, the anion is not particularly limited.
예시적 구현예에서, R1 및 R2는, 각각 독립적으로, X1 또는 X2에 의해 각각 치환된 C1-20 또는 C1-10 선형 또는 분지형의 알킬기로서, X1 또는 X2에 의해 각각 치환된, 메틸기, 에틸기, 프로필기, 부틸기, 펜틸기, 헥실기, 헵실기, 옥틸기, 노닐기, 데실기, 및 이들의 이성질체들로 이루어진 군으로부터 선택되는 것을 포함하는 것일 수 있으나, 이에 제한되지 않을 수 있다. 또는, R1 및 R2는, 하나 이상의 탄소-탄소 이중결합을 포함하는 것일 수 있다. 아울러, R1 및 R2는 동일하거나, 또는 상이할 수 있다.In the exemplary embodiment, R1 and R2 are, each independently, X1 or a respective group of the substituted C1-20 or C1-10 linear or branched by X2, X1 or X2 May be selected from the group consisting of a methyl group, an ethyl group, a propyl group, a butyl group, a pentyl group, a hexyl group, a heptyl group, an octyl group, a nonyl group, a decyl group and isomers thereof, , But may not be limited thereto. Alternatively, R1 and R2 may comprise one or more carbon-carbon double bonds. In addition, R1 and R2 may be the same or different.
예시적 구현예에서, 본원에 따른 알킬-바이올로겐 유도체 화합물은, 양 말단의 치환기 X1 및 X2는 동일하거나, 또는 상이할 수 있다.In an exemplary embodiment, the alkyl-viologen derivative compound according to the present invention may have the same or different substituents X1 and X2 at both ends.
예시적 구현예에서, R3 및R4는, 각각 독립적으로, C1-20 또는 C1-10 선형 또는 분지형의 알킬기로서, 메틸기, 에틸기, 프로필기, 부틸기, 펜틸기, 헥실기, 헵실기, 옥틸기, 노닐기, 데실기, 및 이들의 이성질체들로 이루어진 군으로부터 선택되는 것을 포함하는 것일 수 있으나, 이에 제한되지 않을 수 있다. 예를 들어, R3 및R4는 동일하거나, 또는 상이할 수 있다.In an exemplary embodiment, R <3 > and R4 each independently represents a C1-20 or C1-10 linear or branched alkyl group which may have a substituent such as a methyl group, an ethyl group, a propyl group, a butyl group, a pentyl group, a hexyl group, a heptyl group, Decyl, and isomers thereof, but is not limited thereto. For example, R <3 > and R4 may be the same or different.
본원의 일 구현예에 있어서, 상기 항균 조성물이 물; C1-5 알코올, 예를 들어, 메탄올, 에탄올, 프로판올, 부탄올 또는 펜탄올 등; 테트라하이드로퓨란; 아세톤; 디메틸포름아마이드; 및 이들의 조합들로 이루어진 군으로부터 선택되는 용매를 포함하는 것일 수 있으나, 이에 제한되지 않을 수 있다.In one embodiment of the invention, the antimicrobial composition is water; C1-5 alcohols, such as methanol, ethanol, propanol, butanol or pentanol; Tetrahydrofuran; Acetone; Dimethylformamide; And a solvent selected from the group consisting of combinations thereof.
본원의 일 구현예에 있어서, 상기 알킬-바이올로겐 유도체 화합물은, R1 및 R2가 모두 트리메틸렌기 [-CH2-CH2-CH2-]이고, X1 및 X2가 동일하게, -NH2, -NHCH3, -COOH, 및 -SO3H로 이루어진 군으로부터 선택된 치환기를 가지는 것일 수 있으나, 이에 제한되지 않을 수 있다.In one embodiment of the present application, the alkyl-viologen derivative compound is a compound wherein R1 and R2 are both a trimethylene group [-CH2 -CH2 -CH2 -] and X1 and X2 are the same , -NH2 , -NHCH3 , -COOH, and -SO3 H, but the present invention is not limited thereto.
본원의 일 구현예에 있어서, 상기 알킬-바이올로겐 유도체 화합물의 농도가 약 10 M 이하일 수 있으나, 이에 제한되지 않을 수 있다. 상기 화합물의 농도는, 예를 들어, 약 0.1 nM 내지 약 10 M, 약 0.1 nM 내지 약 5 M, 약 0.1 nM 내지 약 1 M, 약 0.1 nM 내지 약 0.5 M, 약 0.1 nM 내지 약 0.1 M, 약 0.1 nM 내지 약 50 mM, 약 0.1 nM 내지 약 10 mM, 약 0.1 nM 내지 약 1 mM, 약 0.1 nM 내지 약 0.1 mM, 약 0.1 nM 내지 약 50 μM, 약 0.1 nM 내지 약 10 μM, 약 0.1 nM 내지 약 1 μM, 약 0.1 nM 내지 약 0.1 μM, 약 0.1 nM 내지 약 50 nM, 약 0.1 nM 내지 약 10 nM, 약 0.1 nM 내지 약 1 nM, 약 1 nM 내지 약 10 M, 약 10 nM 내지 약 10 M, 약 50 nM 내지 약 10 M, 약 0.1 μM 내지 약 10 M, 약 1 μM 내지 약 10 M, 약 10 μM 내지 약 10 M, 약 50 μM 내지 약 10 M, 약 0.1 mM 내지 약 10 M, 약 1 mM 내지 약 10 M, 약 10 mM 내지 약 10 M, 약 50 mM 내지 약 10 M, 약 0.1 M 내지 약 10 M, 약 0.5 M 내지 약 10 M, 약 1 M 내지 약 10 M, 또는 약 5 M 내지 약 10 M일 수 있으나, 이에 제한되지 않을 수 있다.In one embodiment herein, the concentration of the alkyl-violgen derivative compound may be about 10 M or less, but the present invention is not limited thereto. The concentration of the compound may be, for example, from about 0.1 nM to about 10 M, from about 0.1 nM to about 5 M, from about 0.1 nM to about 1 M, from about 0.1 nM to about 0.5 M, from about 0.1 nM to about 0.1 M, About 0.1 nM to about 10 uM, about 0.1 nM to about 10 mM, about 0.1 nM to about 1 mM, about 0.1 nM to about 0.1 mM, about 0.1 nM to about 50 uM, about 0.1 nM to about 10 uM, from about 0.1 nM to about 10 nM, from about 0.1 nM to about 10 nM, from about 0.1 nM to about 0.1 nM, from about 0.1 nM to about 50 nM, from about 0.1 nM to about 10 nM, from about 0.1 nM to about 1 nM, About 10 M, about 10 M, about 50 M to about 10 M, about 0.1 mM to about 10 M, about 50 M to about 10 M, about 0.1 M to about 10 M, about 1 M to about 10 M, M, from about 1 mM to about 10 M, from about 10 mM to about 10M, from about 50 mM to about 10M, from about 0.1M to about 10M, from about 0.5M to about 10M, from about 1M to about 10M, Or from about 5 M to about 10 M, although it is not limited thereto.
본원의 일 구현예에 있어서, 상기 항균 조성물의 적용 대상 균주는 특별히 제한되지 않는다. 예를 들어, 상기 항균 조성물은, 녹농균 (Pseudomonas aeruginosa), 황색 포도상구균 (Staphylococcus aureus), 폐렴균 (Klebsiella pneumoniae), 클레브시엘라균 (Klebsiella sp.), 대장균 (E.coli), 바실러스균 (Bacillus sp.), 스트렙토코커스 뮤탄스 (Streptococcus mutans), 칸디다균 (Candida albicans), 아스퍼질러스 나이거 (Aspergillus niger), 마이크로코커스균 (Micrococcus sp.), 스테필로코커스균 (Staphylococcus sp.), 엔테로박터균 (Enterobacter sp.), 비브리오균 (Vibrio sp.), 에드워드지엘라균 (Edwardsiella sp.), 및 이들의 조합들로 이루어진 군으로부터 선택되는 균주를 포함하는 것에 대해 항균 활성을 갖는 것일 수 있으나, 이에 제한되지 않을 수 있다. 예를 들어, 상기 항균 조성물이, 녹농균 (Pseudomonas aeruginosa), 황색 포도상구균 (Staphylococcus aureus), 폐렴균 (Klebsiella pneumoniae), 및 이들의 조합들로 이루어진 군으로부터 선택되는 균주를 포함하는 것에 대해 항균 활성을 갖는 것일 수 있으나, 이에 제한되지 않을 수 있다.
In one embodiment of the present invention, the strain to which the antimicrobial composition is applied is not particularly limited. For example, the antimicrobial composition may be selected from the group consisting of Pseudomonas aeruginosa, Staphylococcus aureus, Klebsiella pneumoniae, Klebsiella sp., E. coli, Bacillus sp. Bacillus sp., Streptococcus mutans, Candida albicans, Aspergillus niger, Micrococcus sp., Staphylococcus sp., Staphylococcus sp. A strain selected from the group consisting of Enterobacter sp., Vibrio sp., Edwards iella sp., And combinations thereof. However, the present invention is not limited thereto. For example, when the antimicrobial composition comprises a strain selected from the group consisting of Pseudomonas aeruginosa, Staphylococcus aureus, Klebsiella pneumoniae, and combinations thereof, But may not be limited thereto.
본원의 제 2 측면은, 하기 화학식 1로서 표시되는 알킬-바이올로겐 유도체 화합물을 포함하는 상기 본원의 제 1 측면에 따른 항균 조성물을 기재에 도포하는 것을 포함하는, 표면 항균처리 방법을 제공한다:A second aspect of the invention provides a method of surface antimicrobial treatment comprising applying to the substrate an antimicrobial composition according to the first aspect of the invention comprising an alkyl-viologen derivative compound represented by the following formula:
[화학식 1][Chemical Formula 1]
; ;
화학식 1에서,In formula (1)
R1, R2, X1 및 X2는, 상기 본원의 제 1 측면에서 정의된 바와 같음.R1 , R2 , X1 and X2 are as defined in the first aspect of the present invention.
종래의 항균물질들은 그 특성상 용출 타입보다도 접촉 타입으로의 적용이 제한적이다. 그러나 본원에 따른 상기 화학식 1의 화합물들은 양 말단에 아민기 등을 가지고 있기 때문에 이를 이용한 친핵성 반응을 통해 플라스틱, 섬유 또는 고분자 등 다양한 기재 또는 물질의 표면에 배치시키거나 [Royal Society of Chemistry: RSC Advances, 2013, vol. 3, 2509-2519], 산화물 또는 칼코지나이드 표면에 자기조립 흡착 등의 과정을 거쳐 안정하게 고정시킬 수 있다. 이때 적용되는 고분자, 섬유, 플라스틱 등 다양한 기재 또는 물질들이 친핵성 반응이 가능한 경우 본원에 따른 항균 조성물을 그 표면에 안정하게 배치할 수 있으며, 친핵성 반응이 매우 느리거나 어려운 경우에는 상기와 같은 다양한 기재 또는 물질의 원제에 잘 배합하여 사출 성형과정을 통해 항균특성을 발현시킬 수 있다.Conventional antimicrobial materials have limited application to the contact type than the elution type due to their characteristics. However, since the compounds of formula (1) according to the present invention have amine groups at both ends thereof, they are placed on the surface of various substrates or materials such as plastics, fibers or polymers through nucleophilic reactions using them [Royal Society of Chemistry: RSC Advances, 2013, vol. 3, 2509-2519], self-assembled adsorption onto the oxide or chalcogenide surface, and the like. When various substrates or substances such as polymers, fibers, plastics, etc., which are applied at this time, are capable of nucleophilic reaction, the antimicrobial composition according to the present invention can be stably placed on the surface thereof. When the nucleophilic reaction is very slow or difficult, The antimicrobial property can be expressed through an injection molding process by being well mixed with the base material or the raw material of the substance.
본원의 일 구현예에 있어서, 상기 항균 조성물은 물; C1-5 알코올, 예를 들어, 메탄올, 에탄올, 프로판올, 부탄올 또는 펜탄올 등; 테트라하이드로퓨란; 아세톤; 디메틸포름아마이드; 및 이들의 조합들로 이루어진 군으로부터 선택되는 용매를 포함하는 것일 수 있으나, 이에 제한되지 않을 수 있다.In one embodiment of the invention, the antimicrobial composition comprises water; C1-5 alcohols, such as methanol, ethanol, propanol, butanol or pentanol; Tetrahydrofuran; Acetone; Dimethylformamide; And a solvent selected from the group consisting of combinations thereof.
상기 항균 조성물을 기재에 도포하는 것은, 상기 항균 조성물에 상기 기재를 침지하여 상기 기재 표면을 도포하는 것일 수 있다. 이때, 상기 도포는 상기 기재의 일면에만 수행되는 것일 수 있고, 또는 양면 모두에 수행되는 것일 수 있다. 상기 기재의 일면에만 도포되도록 하는 경우, 파라핀 등의 마스킹 물질을 다른 일면에 도포하고 파라핀이 일면에 도포된 기재를 상기 용액에 침지하여 수행되는 것일 수 있으나, 이에 제한되지 않을 수 있다. 상기 마스킹 물질 도포는 파라핀 외에도 당업계에서 통상적으로 사용되는 물질을 이용하여 알려진 통상적인 방법을 통하여 수행될 수 있다.The application of the antimicrobial composition to the substrate may be to immerse the substrate in the antimicrobial composition to apply the substrate surface. At this time, the application may be performed only on one side of the substrate, or may be performed on both sides. In the case of applying to only one side of the substrate, it may be carried out by applying a masking material such as paraffin to the other side and immersing the substrate coated with paraffin on the side of the substrate. However, the present invention is not limited thereto. The masking material application may be carried out by a conventional method using materials commonly used in the art besides paraffin.
본원의 일 구현예에 있어서, 상기 기재는 특별히 제한되지 않는다. 예를 들어, 상기 기재는, 폴리에틸렌 테레프탈레이트 (PET), 폴리에틸렌 설폰 (PES), 폴리에틸렌 나프탈레이트 (PEN), 폴리에스테르 (polyester), 폴리카보네이트 (PC), 폴리메틸메타크릴레이트 (PMMA), 폴리이미드 (PI), 에틸렌비닐아세테이트 (EVA), 폴리카프로락탐 (polycaprolactame), 폴리카프로락톤 (polycaprolactone), 폴리락트산 (polylactic acid), 폴리글리콜산 (polyglycolic acid), 폴리우레탄 (polyurethane), 폴리(3-하이드록시부틸레이트-코-3-하이드록시발레이트 (poly(3-hydroxybutyrate-co-3-hydroxyvalerate: PHBV), 나일론 (nylon), 폴리비닐클로라이드 (polyvinylchloride: PVC), 폴리아크릴레이트 (polyacrylate), 폴리라이신 (polylysine), 폴리사카라이드 (polysaccharide), 폴리펩타이드 (polypeptide), 폴리뉴클레오타이드 (polynucleotide), 산화폴리에틸렌 (polyethylene oxide), 폴리포스파젠 (polyphosphazene), 아몰포스폴리에틸렌테레프탈레이트 (APET), 폴리프로필렌테레프탈레이트 (PPT), 폴리에틸렌테레프탈레이트글리세롤 (PETG), 폴리사이클로헥실렌디메틸렌테레프탈레이트 (PCTG), 변성트리아세틸셀룰로스 (TAC), 폴리아릴레이트 (PAR), 폴리다이메틸실록세인 (PDMS), 실리콘 수지, 불소 수지, 변성 에폭시 수지, 테프론, 및 이들의 공중합체; 면 (cotton); 파이버 글라스; 인듐 주석 화합물 (ITO) 필름; 및 금속 필름으로 이루어진 군으로부터 선택되는 것을 포함하는 것일 수 있으나, 이에 제한되지 않을 수 있다. 본원에 따른 상기 조성물은 상기 기재의 종류 및 도포 방법에 특별히 제한 없이 사용될 수 있다.In one embodiment of the invention, the substrate is not particularly limited. For example, the substrate may be made of a material selected from the group consisting of polyethylene terephthalate (PET), polyethylene sulfone (PES), polyethylene naphthalate (PEN), polyester, polycarbonate (PC), polymethyl methacrylate (PI), ethylene vinyl acetate (EVA), polycaprolactame, polycaprolactone, polylactic acid, polyglycolic acid, polyurethane, poly (3) Hydroxybutyrate-co-3-hydroxyvalerate (PHBV), nylon, polyvinylchloride (PVC), polyacrylate, Polylysine, polysaccharides, polypeptides, polynucleotides, polyethylene oxide, polyphosphazene, amorphous polyesters, polysaccharides, polysaccharides, polysaccharides, (PET), polycyclohexylenedimethylene terephthalate (PCTG), modified triacetylcellulose (TAC), polyarylate (PAR), polyacrylonitrile From the group consisting of polydimethylsiloxane (PDMS), silicone resin, fluorine resin, modified epoxy resin, Teflon, and copolymers thereof; cotton; fiberglass; indium tin compound (ITO) But the present invention is not limited thereto. The composition according to the present invention can be used in the kind of the substrate and the method of applying it without particular limitation.
예시적 구현예에서, 상기 항균 조성물이 물을 용매로서 포함하는 경우, 상기 항균 조성물을 기재에 도포하는 것은 약 100℃ 이하의 온도에서 수행되는 것일 수 있으나, 이에 제한되지 않을 수 있다. 예를 들어, 물 외에 다른 용매를 사용할 경우 도포 온도는, 사용하는 용매의 끓는점 이하의 적절한 온도일 수 있으나, 이에 제한되지 않을 수 있다.In an exemplary embodiment, when the antimicrobial composition comprises water as a solvent, the application of the antimicrobial composition to the substrate may be performed at a temperature of about 100 캜 or less, but may not be limited thereto. For example, when a solvent other than water is used, the application temperature may be an appropriate temperature below the boiling point of the solvent used, but may not be limited thereto.
예시적 구현예에서, 상기 항균 조성물이 상기 기재에 도포되는 두께는, 특별히 제한되지 않는다. 예를 들어, 상기 항균 조성물의 도포막 두께는 단분자 층의 두께일 수 있고, 또는 약 1 ㎛ 이하 또는 약 100 nm 이하일 수 있으나, 이에 제한되지 않을 수 있다.
In an exemplary embodiment, the thickness to which the antimicrobial composition is applied to the substrate is not particularly limited. For example, the coating film thickness of the antimicrobial composition may be a monomolecular layer thickness, or may be about 1 탆 or less, or about 100 nm or less, but is not limited thereto.
본원의 제 2 측면에 있어서, 본원의 제 1 측면과 중복되는 부분들에 대해서는 상세한 설명을 생략하였으나, 본원의 제 1 측면에 대해 설명한 내용은 본원의 제 2 측면에서 그 설명이 생략되었더라도 동일하게 적용될 수 있다.
In the second aspect of the present invention, the detailed description of the parts overlapping with the first aspect of the present application is omitted, but the description of the first aspect of the present application is applied equally to the second aspect of the present invention .
이하, 본원에 대하여 실시예를 이용하여 좀더 구체적으로 설명하지만, 하기 실시예는 본원의 이해를 돕기 위하여 예시하는 것일 뿐, 본원의 내용이 하기 실시예에 한정되는 것은 아니다.
Hereinafter, the present invention will be described in more detail with reference to Examples. However, the following Examples are given for the purpose of helping understanding of the present invention, but the present invention is not limited to the following Examples.
[실시예][Example]
실시예 1Example 1
디-(3-아미노프로필)-바이올로겐 (이하, DAPV)을 각각 1 nM, 1 μM, 1 mM, 1 M 농도가 되도록 물에 용해시켰다. 아가 플레이트에 상기 DAPV 용액을 농도별로 각각 20 ㎕씩 혼합시킨 후, 상기 다양한 농도의 DAPV 처리된 아가 플레이트에 Pseudomonas aeruginosa 균주를 도말하고 37℃의 온도에서 16 시간 동안 배양시켰다. 그 실험 결과를 도 1에 나타내었다.Di- (3-aminopropyl) -viologen (hereinafter referred to as DAPV) was dissolved in water to a concentration of 1 nM, 1 μM, 1 mM and 1 M, respectively. Each of the DAPV solutions was mixed with 20 μl of each of the DAPV solutions on the agar plate, and then Pseudomonas aeruginosa strain was plated on the DAPV-treated agar plates at various concentrations and cultured at 37 ° C for 16 hours. The experimental results are shown in Fig.
도 1에 나타난 바와 같이, DAPV의 농도가 1 nM 인 경우는 균주가 배양되었지만, 1 μM 이상의 농도로 DAPV를 혼합한 아가 플레이트에서는 균주가 배양되지 않았음이 확인되었고, 이에 의하여 상기 DAPV가 항균활성이 있음을 알 수 있었다.
As shown in FIG. 1, when the concentration of DAPV was 1 nM, the strain was cultured. However, it was confirmed that the strain was not cultured in the agar plate mixed with DAPV at a concentration of 1 μM or more, .
실시예 2Example 2
1,1'-비스(3-카르복시프로필)-4,4'-비피리딘-1,1'-디움 (HOOC-CH2-CH2-CH2-N+C5H4-N+C5H4-CH2-CH2-CH2-COOH (이하, DCPV)을 각각 1 nM, 1 μM, 1 mM, 1 M 농도가 되도록 물에 용해시켰다. 아가 플레이트에 상기 DCPV 용액을 농도별로 각각 20 ㎕씩 혼합시킨 후, 상기 다양한 농도의 DCPV 처리된 아가 플레이트에 Pseudomonas aeruginosa 균주를 도말하고 37℃의 온도에서 16 시간 동안 배양시켰다.(3-carboxypropyl) -4,4'-bipyridine-1,1'-dime (HOOC-CH2 -CH2 -CH2 -N+ C5 H4 -N+ C5 H4 -CH2 -CH2 -CH2 -COOH (hereinafter referred to as DCPV) was dissolved in water to a concentration of 1 nM, 1 μM, 1 mM and 1 M, respectively. The DCPV solution was added to the agar plate Mu] l, and then the Pseudomonas aeruginosa strain was plated on the DCPV-treated agar plates at various concentrations and cultured at a temperature of 37 [deg.] C for 16 hours.
배양 결과, DCPV의 농도가 1 nM 인 경우는 균주가 배양되었지만, 1 μM 이상의 농도로 DCPV를 혼합한 아가 플레이트에서는 균주가 배양되지 않았음이 확인되었고, 이에 의하여 상기 DCPV가 항균활성이 있음을 알 수 있었다.
As a result, when the concentration of DCPV was 1 nM, the strain was cultured. However, it was confirmed that the strain was not cultured in the agar plate mixed with DCPV at a concentration of 1 μM or more. Thus, it was confirmed that the DCPV had antibacterial activity I could.
실시예 3Example 3
1,1'-비스(3-설포프로필)-4,4'-비피리딘-1,1'-디움 (HO3S-CH2-CH2-CH2-N+C5H4-N+C5H4-CH2-CH2-CH2-SO3H (이하, DSPV)을 각각 1 nM, 1 μM, 1 mM, 1 M 농도가 되도록 물에 용해시켰다. 아가 플레이트에 상기 DSPV 용액을 농도별로 각각 20 ㎕씩 혼합시킨 후, 상기 다양한 농도의 DSPV처리된 아가 플레이트에 Pseudomonas aeruginosa 균주를 도말하고 37℃의 온도에서 16 시간 동안 배양시켰다.Bis (3-sulfopropyl) -4,4'-bipyridine-1,1'-dime (HO3 S-CH2 -CH2 -CH2 -N+ C5 H4 -N+ C5 H4 -CH2 -CH2 -CH2 -SO3 H (hereinafter referred to as DSPV) was dissolved in water to a concentration of 1 nM, 1 μM, 1 mM and 1 M, respectively. 20 [mu] l of each concentration was added to each of the concentrations, and Pseudomonas aeruginosa strain was plated on the DSPV-treated agar plates at various concentrations and cultured at a temperature of 37 [deg.] C for 16 hours.
배양 결과, DSPV의 농도가 1 nM 인 경우는 균주가 배양되었지만, 1 μM 이상의 농도로 DSPV를 혼합한 아가 플레이트에서는 균주가 배양되지 않았음이 확인되었고, 이에 의하여 상기 DSPV가 항균활성이 있음을 알 수 있었다.
As a result, when the concentration of DSPV was 1 nM, the strain was cultured. However, it was confirmed that the strain did not cultivate in the agar plate mixed with DSPV at a concentration of 1 μM or more, I could.
실시예 4Example 4
1,1'-비스(3-(메틸아미노)프로필)-4,4'-비피리딘-1,1'-디움 (CH3NH-CH2-CH2-CH2-N+C5H4-N+C5H4-CH2-CH2-CH2-NHCH3 (이하, DMAPV)을 각각 1 nM, 1 μM, 1 mM, 1 M 농도가 되도록 물에 용해시켰다. 아가 플레이트에 상기 DMAPV 용액을 농도별로 각각 20 ㎕씩 혼합시킨 후, 상기 다양한 농도의 DMAPV 처리된 아가 플레이트에 Pseudomonas aeruginosa 균주를 도말하고 37℃의 온도에서 16 시간 동안 배양시켰다.(CH3 NH-CH2 -CH2 -CH2 -N+ C5 H4 (CH3) -N+ C5 H4 -CH2 -CH2 -CH2 -NHCH3 (hereinafter referred to as DMAPV) was dissolved in water to a concentration of 1 nM, 1 μM, 1 mM and 1 M, respectively. The solution was mixed with 20 쨉 l of each concentration, and Pseudomonas aeruginosa strain was plated on DMAPV-treated agar plates at various concentrations and cultured at a temperature of 37 캜 for 16 hours.
배양 결과, DMAPV의 농도가 1 nM 인 경우는 균주가 배양되었지만, 1 μM 이상의 농도로 DMAPV를 혼합한 아가 플레이트에서는 균주가 배양되지 않았음이 확인되었고, 이에 의하여 상기 DMAPV가 항균활성이 있음을 알 수 있었다.
As a result, when the concentration of DMAPV was 1 nM, the strain was cultured. However, it was confirmed that the strain was not cultured in agar plates mixed with DMAPV at a concentration of 1 μM or more. Thus, it was confirmed that DMAPV had antibacterial activity I could.
실시예 5Example 5
Pseudomonas aeruginosa 균주를 37℃의 온도에서 16 시간 동안 배양하였다. 디-(3-아미노프로필)-바이올로겐 (DAPV)을 각각 1 nM, 1 μM, 1 mM, 1 M 농도가 되도록 물에 용해시켰다. 직경 1 cm 크기의 페이퍼 디스크에 상기 DAPV 용액을 농도별로 각각 20 ㎕씩 흡수시킨 후, 상기 DAPV 용액을 흡수시킨 상기 페이퍼 디스크를 상기 배양된 균주 상에 위치시켰다.The strain Pseudomonas aeruginosa was incubated at 37 캜 for 16 hours. Di- (3-aminopropyl) -biorogen (DAPV) was dissolved in water to a concentration of 1 nM, 1 μM, 1 mM and 1 M, respectively. Each 20 μl of the DAPV solution was absorbed into a paper disk having a diameter of 1 cm each, and the paper disk absorbing the DAPV solution was placed on the cultured strain.
그 실험 결과를 도 2에 나타내었고, 균주 배양이 억제된 영역의 지름을 측정하여 도 3에 나타내었다.The results of the experiment are shown in Fig. 2, and the diameters of the regions where the culture was inhibited were measured and shown in Fig.
도 2 및 도 3에 나타난 바와 같이, DAPV의 농도가 nM 수준인 경우에도 균주 배양이 억제됨을 보이고, 또한, 농도가 높을수록 균주 배양이 억제되는 영역이 넓어짐을 알 수 있었다.
As shown in FIG. 2 and FIG. 3, when the concentration of DAPV was nM level, the culture of the strain was inhibited, and it was found that the concentration of the DAPV was inhibited.
실시예 6Example 6
디-(3-아미노프로필)-바이올로겐 (DAPV)을 각각 1 nm, 1 μM, 1 mM 농도가 되도록 물에 용해시키고, 메틸 바이올로겐 또한 각각 1 nM, 1 μM, 1 mM 농도가 되도록 물에 용해시켰다. 직경 1 cm 크기의 페이퍼 디스크에 상기 DAPV 용액 및 상기 메틸 바이올로겐 용액을 농도별로 각각 20 ㎕씩 흡수시킨 후, 상기 페이퍼 디스크를 플레이트 상에 위치시켰다. 여기에, Pseudomonas aeruginosa 균주를 도말하고 37℃의 온도에서 16 시간 동안 배양시켰다. 그 실험 결과를 도 4에 나타내었다.(DAPV) was dissolved in water to a concentration of 1 nM, 1 μM, and 1 mM, respectively. The concentration of methyl viologen was also 1 nM, 1 μM, and 1 mM, respectively. And dissolved in water. Each of the DAPV solution and the methyl viologen solution was absorbed by 20 쨉 l per concentration on a paper disk having a diameter of 1 cm, and the paper disk was placed on the plate. Here, the Pseudomonas aeruginosa strain was plated and incubated at a temperature of 37 DEG C for 16 hours. The experimental results are shown in Fig.
도 4에 나타난 바와 같이, DAPV는 농도 1 nM 인 경우에도 그 주변에서 균주 배양이 억제됨이 관찰되었고 (B), 그 농도가 높을수록 배양 억제 영역이 넓어짐을 확인할 수 있었지만, 메틸 바이올로겐을 처리한 경우에는 항균활성을 확인할 수 없었으며, 그 농도가 증가해도 큰 차이가 나타나지 않았다 (A).
As shown in FIG. 4, the culture of DAPV was inhibited even at a concentration of 1 nM (B), and it was confirmed that the culture inhibition zone was broader as the concentration was increased, but the methyl biologen In one case, the antimicrobial activity could not be confirmed, and even when the concentration was increased, there was no significant difference (A).
실시예 7Example 7
디-(3-아미노프로필)-바이올로겐 (DAPV)을 물에 용해시켜 1 wt% DAPV 용액을 제조하였다. 상기 DAPV 용액을 40℃로 가열한 후, 여기에 PET 필름을 침지하였다. 이때, 상기 PET 필름을 상기 DAPV 용액에 침지하고 20 분 후, 침지된 PET 필름을 꺼내어 접촉각 (Phoenicx 150, SEO Co.)을 측정하였다.Di- (3-aminopropyl) -violojen (DAPV) was dissolved in water to prepare a 1 wt% DAPV solution. After the DAPV solution was heated to 40 캜, a PET film was immersed in the solution. At this time, 20 minutes after immersing the PET film in the DAPV solution, the immersed PET film was taken out and the contact angle (Phenicx 150, SEO Co.) was measured.
그 결과, 침지하기 전 PET 필름의 초기 접촉각이 85 도 (°)인 반면, DAPV 용액에 20 분간 침지한 PET 필름의 접촉각은 34 도로 측정되었고, DAPV 용액에 침지한 PET 필름은 강한 침수성을 보임을 알 수 있었다. 이는 DAPV가 아미노분해 (aminolysis)를 통해 PET 표면에 결합되어, PET가 성공적으로 표면 개질되었음을 증명하는 결과이다.
As a result, the contact angle of the PET film immersed in the DAPV solution for 20 minutes was 34 degrees, while the initial contact angle of the PET film before immersion was 85 degrees (°), and the PET film immersed in the DAPV solution showed strong immersion And it was found. This is the result of DAPV being bound to the PET surface through aminolysis and demonstrating successful surface modification of the PET.
실험예 1: 폴리에스테르 원단을 이용한Experimental Example 1: Using polyester fabric항균도 측정Antimicrobial measurement
항균도 측정을 위하여, 폴리에스테르 원단을 표준포로서 이용하고 DAPV를 실시예 7에 준하여 처리한 후 여기에 균주 1 (Staphylococcus aureus ATC 6538; 황색 포도상구균) 및 균주 2 (Klebsiella pneumoniae ATCC 4352; 폐렴균)를 접종하고 KS K0639: 2011의 측정방법을 이용하여 항균도를 다음과 같이 측정하였다. 이때, 대조군은 아무것도 처리하지 않은 폴리에스테르 원단에 균주를 접종하고 18 시간 동안 동일한 조건에서 유지시킨 것이다. 그 결과를 하기 표 1과 도 5a 및 도 5b에 나타내었다.For the measurement of the antimicrobial activity, DAPV was treated according to Example 7 using polyester fabric as a standard cloth, and Staphylococcus aureus ATC 6538 (Staphylococcus aureus) and Streptococcus 2 (
[표 1][Table 1]
표 1과 도 5a 및 도 5b에 나타난 바와 같이, 아무것도 처리하지 않은 대조군은 18 시간 후 세균수가 증가하였으나, DAPV가 적용된 시료에서는 균주들이 사멸되어 균주 1 및 균주 2 모두 99.9%까지 현저하게 균수가 감소하는 것을 확인할 수 있었다. 이러한 결과는 전술한 바와 같이 알킬-바이올로겐의 살균 및 항균 작용에 의한 것이다.
As shown in Table 1 and FIG. 5A and FIG. 5B, the number of bacteria was increased after 18 hours in the control group without any treatment, but in the samples to which DAPV was applied, the strains were killed and 99.5% of the
실험예 2: 면 원단을 이용한Experimental Example 2: Using cotton fabric항균도 측정Antimicrobial measurement
항균도 측정을 위하여, 면 (cotton) 원단을 표준포로서 이용하고 DAPV를 실시예 7에 준하여 처리한 후 여기에 균주 1 (Staphylococcus aureus ATC 6538; 황색 포도상구균) 및 균주 2 (Klebsiella pneumoniae ATCC 4352; 폐렴균)를 접종하고 KS K0639: 2011의 측정방법을 이용하여 항균도를 다음과 같이 측정하였다. 이때, 대조군은 아무것도 처리하지 않은 면 원단에 균주를 접종하고 18 시간 동안 동일한 조건에서 유지시킨 것이다. 그 결과를 하기 표 2와 도 6a 및 도 6b에 나타내었다.For the measurement of antibacterial activity, DAPV was treated according to Example 7 using cotton fabric as a standard bell, and Staphylococcus aureus ATC 6538 (Staphylococcus aureus) and Streptococcus 2 (
[표 2][Table 2]
표 2와 도 6a 및 도 6b에 나타난 바와 같이, 아무것도 처리하지 않은 대조군은 18 시간 후 세균수가 증가하였으나, DAPV가 적용된 시료에서는 균주들이 사멸되어 균주 1 및 균주 2 모두 99.9%까지 현저하게 균수가 감소하는 것을 확인할 수 있었다. 이러한 결과는 전술한 바와 같이 알킬-바이올로겐의 살균 및 항균 작용에 의한 것이다.
As shown in Table 2 and FIG. 6A and FIG. 6B, the number of bacteria increased after 18 hours in the control group treated with nothing, but in the samples to which DAPV was applied, the strains were killed and 99.5% of the
실험예 3: 항균력 측정Experimental Example 3: Measurement of antibacterial activity
항균력 측정을 위하여, Stomacher 400 POLY-BAG을 표준필름으로 이용하고 DAPV를 실시예 7에 준하여 처리한 후 여기에 균주 1 (Staphylococcus aureus ATC 6538; 황색 포도상구균) 및 균주 2 (Escherichia coli ATCC 8739; 대장균)를 접종하고 항균력 (JIS Z 2801: 2010, 밀착필름법)을 다음과 같이 측정하였다. 이때, 시험균액을 35±1℃의 온도, 90%의 상대습도에서 24 시간 동안 정치 배양한 후 1 cm2당 균수를 측정하였고, 대조군은 아무것도 처리하지 않은 Stomacher 400 POLY-BAG 필름에 균주를 접종하고 24 시간 동안 동일한 조건에서 배양시킨 것이다. 그 결과를 하기 표 3과 도 7a 및 도 7b에 나타내었다.To measure the antibacterial activity, Stomacher 400 POLY-BAG was used as a standard film and DAPV was treated according to Example 7. Staphylococcus aureus ATC 6538 and Staphylococcus aureus ATCC 8739 ) And the antibacterial activity (JIS Z 2801: 2010, adhesion film method) was measured as follows. At this time, the test strain was incubated for 24 hours at a temperature of 35 ± 1 ° C. and a relative humidity of 90%, and the number of bacteria per 1 cm2 was measured. In the control group, a strain was inoculated on a Stomacher 400 POLY-BAG film And cultured under the same conditions for 24 hours. The results are shown in Table 3 and Figs. 7A and 7B.
[표 3][Table 3]
표 3과 도 7a 및 도 7b에 나타난 바와 같이, 아무것도 처리하지 않은 대조군은 24 시간 후 세균수가 증가하였으나, DAPV가 적용된 시료에서 균주들이 1 cm2당 0.63까지 현저하게 감소하는 것을 확인할 수 있었다. 상기 항균활성치는 2.0 log 이상이면 항균효과가 있음을 나타내는 수치로서, DAPV를 처리한 시료의 경우 균주 1 및 균주 2에서 각각 4.5, 6.3을 나타내어, 전술한 바와 같이 알킬-바이올로겐의 살균 및 항균 작용이 우수함을 확인할 수 있다.
As shown in Table 3 and Figs. 7a and 7b, the number of bacteria was increased after 24 hours in the control group treated with nothing, but it was confirmed that the number of the strains was significantly reduced to 0.63 per 1 cm2 in the DAPV-applied samples. In the case of DAPV-treated samples, the
실시예 8Example 8
디-(3-아미노프로필)-바이올로겐 (DAPV)을 물에 용해시켜 1 wt% 용액을 제조하였다. 상기 DAPV 용액을 40℃로 가열한 후, 여기에 알루미나가 코팅된 유리슬라이드를 침지하여 그 표면을 개질시켰다. 이때, 상기 유리 슬라이드를 상기 DAPV 용액에 침지하고 20 분 후, 침지된 유리 슬라이드를 꺼내어 접촉각 (contact angle)을 측정하였다. 그 결과, 표면 개질 전 알루미나가 코팅된 유리 슬라이드의 초기 접촉각이 10 도인 반면, DAPV 용액에 20 분간 침지하여 표면 개질된 유리 슬라이드의 접촉각은 39 도로 측정되었다. 침지 후 표면 개질된 유리 슬라이드의 물 접촉각은 알킬-바이올로겐이 나타내는 접촉각과 유사한 것으로서, 이러한 결과로부터 유리 슬라이드 표면에 알킬-바이올로겐이 존재함을 알 수 있었다.
A 1 wt% solution was prepared by dissolving di- (3-aminopropyl) -violojen (DAPV) in water. After the DAPV solution was heated to 40 캜, a glass slide coated with alumina was immersed therein to modify the surface thereof. At this time, 20 minutes after immersing the glass slide in the DAPV solution, the immersed glass slide was taken out and the contact angle was measured. As a result, the initial contact angle of the glass slide coated with alumina before the surface modification was 10 degrees, while the contact angle of the surface modified glass slide was measured at 39 degrees by immersing in the DAPV solution for 20 minutes. The water contact angle of the surface modified glass slide after immersion was similar to that of the alkyl-viologen. From these results, it was found that the alkyl-biolgen was present on the surface of the glass slide.
실시예 9Example 9
디-(3-아미노프로필)-바이올로겐 (DAPV)을 물에 용해시켜 1 wt% 용액을 제조하였다. 상기 DAPV 용액을 40℃로 가열한 후, 여기에 Tin-doped Indiumoxide (ITO) 슬라이드를 침지하여 그 표면을 개질시켰다. 이때, 상기 ITO 슬라이드를 상기 DAPV 용액에 침지하고 20 분 후, 침지된 ITO 슬라이드를 꺼내어 접촉각 (contact angle)을 측정하였다. 그 결과, 표면 개질 전 ITO 슬라이드의 초기 접촉각이 20 도인 반면, DAPV 용액에 20 분간 침지되어 표면 개질된 ITO 슬라이드의 접촉각은 39 도 측정되었다. 침지 후 표면 개질된 ITO 슬라이드의 물 접촉각은 알킬-바이올로겐이 나타내는 접촉각과 유사한 것으로서, 이러한 결과로부터 ITO 슬라이드 표면에 알킬-바이올로겐이 존재함을 알 수 있었다.
A 1 wt% solution was prepared by dissolving di- (3-aminopropyl) -violojen (DAPV) in water. The DAPV solution was heated to 40 ° C., and a surface of the DAPV solution was modified by immersing a tin-doped indium oxide (ITO) slide thereon. At this time, the ITO slides were immersed in the DAPV solution, and after 20 minutes, the immersed ITO slides were taken out and the contact angle was measured. As a result, the initial contact angle of the ITO slides before surface modification was 20 degrees, while the contact angle of the ITO slides immersed in the DAPV solution for 20 minutes was 39 degrees. The water contact angle of the surface modified ITO slides after immersion was similar to the contact angle indicated by the alkyl-viologen. From these results, it was found that alkyl-biolgen was present on the ITO slide surface.
실시예 11Example 11
수성 페인트 (제품명: 멀티플러스 다용도 수용도료, 노루페인트)에 디-(3-아미노프로필)-바이올로겐 (DAPV)이 1 wt% 포함되도록 용해시켜 스프레이 건을 이용하여 폴리스타이렌 필름 위에 도막을 형성하였다. 상기 도막에 균주 1 (Staphylococcus aureus ATC 6538; 황색 포도상구균) 및 균주 2 (Klebsiella pneumoniae ATCC 4352; 폐렴균)를 접종하고 항균력 (JIS Z 2801: 2010, 밀착필름법)을 다음과 같이 측정하였다. 이때, 시험균액을 35±1℃의 온도, 90%의 상대습도에서 24 시간 동안 정치 배양한 후 1 cm2당 균수를 측정하였고, 대조군은 아무것도 처리하지 않은 수성페인트 도막에 균주를 접종하고 24 시간 동안 동일한 조건에서 배양시킨 것이다. 그 결과를 하기 표 4에 나타내었다.(3-aminopropyl) -viologen (DAPV) was dissolved in water-based paint (product name: multi-purpose water-soluble paint, noru paint) to form a film on the polystyrene film using a spray gun . Staphylococcus aureus ATC 6538 (Staphylococcus aureus) and Strain 2 (Klebsiella pneumoniae ATCC 4352) were inoculated on the coating film and the antibacterial activity (JIS Z 2801: 2010, adhesion film method) was measured as follows. At that time, the test strain was incubated for 24 hours at a temperature of 35 ± 1 ° C. and a relative humidity of 90%, and the number of bacteria per 1 cm2 was measured. In the control group, the strain was inoculated into a water- Lt; / RTI > under the same conditions. The results are shown in Table 4 below.
[표 4][Table 4]
표 4에 나타낸 바와 같이, 아무것도 처리하지 않은 대조군은 24 시간 후 세균수가 증가하였으나, DAPV가 적용된 페인트 도막 시료에서는 균주들이 1 cm2당 0.63까지 현저하게 감소하는 것을 확인할 수 있었다. 상기 항균활성치는 2.0 log 이상이면 항균효과가 있음을 나타내는 수치로서, DAPV를 처리한 시료의 경우 균주 1 및 균주 2에서 각각 4.5, 6.3을 나타내어, 전술한 바와 같이 알킬-바이올로겐을 수성 페인트에 적용할 경우에도 살균 및 항균 작용이 우수함을 확인할 수 있다.
As shown in Table 4, the number of bacteria was increased after 24 hours in the control group without any treatment, but it was confirmed that the number of bacteria in the paint film sample to which DAPV was applied significantly decreased to 0.63 per cm2 . In the case of DAPV-treated samples, the
전술한 본원의 설명은 예시를 위한 것이며, 본원이속하는 기술분야의 통상의 지식을 가진 자는 본원의 기술적 사상이나 필수적인 특징을 변경하지 않고서 다른 구체적인 형태로 쉽게 변형이 가능하다는 것을 이해할 수 있을 것이다. 그러므로 이상에서 기술한 실시예들은 모든 면에서 예시적인 것이며 한정적이 아닌 것으로 이해해야만 한다. 예를 들어, 단일형으로 설명되어 있는 각 구성 요소는 분산되어 실시될 수도 있으며, 마찬가지로 분산된 것으로 설명되어 있는 구성 요소들도 결합된 형태로 실시될 수도 있다.The foregoing description of the disclosure is exemplary, It will be understood by those skilled in the art that various changes in form and details may be made therein without departing from the spirit and scope of the invention as defined by the appended claims. It is therefore to be understood that the above-described embodiments are illustrative in all aspects and not restrictive. For example, each component described as a single entity may be distributed and implemented, and components described as being distributed may also be implemented in a combined form.
본원의 범위는 상기 상세한 설명보다는 후술하는 특허청구범위에 의하여 나타내어지며, 특허청구범위의 의미 및 범위, 그리고 그 균등 개념으로부터 도출되는 모든 변경 또는 변형된 형태가 본원의 범위에 포함되는것으로 해석되어야 한다.
The scope of the present invention is defined by the appended claims rather than the detailed description, and all changes or modifications derived from the meaning and scope of the claims and their equivalents are included in the scope of the present invention .
| Application Number | Priority Date | Filing Date | Title |
|---|---|---|---|
| KR1020130123423AKR101565012B1 (en) | 2013-10-16 | 2013-10-16 | Antibacterial composition and surface antibacterial treatment method using the same |
| PCT/KR2014/009712WO2015056984A1 (en) | 2013-10-16 | 2014-10-16 | Antibacterial composition and antibacterial surface treatment method using same |
| Application Number | Priority Date | Filing Date | Title |
|---|---|---|---|
| KR1020130123423AKR101565012B1 (en) | 2013-10-16 | 2013-10-16 | Antibacterial composition and surface antibacterial treatment method using the same |
| Publication Number | Publication Date |
|---|---|
| KR20150044256A KR20150044256A (en) | 2015-04-24 |
| KR101565012B1true KR101565012B1 (en) | 2015-11-02 |
| Application Number | Title | Priority Date | Filing Date |
|---|---|---|---|
| KR1020130123423AActiveKR101565012B1 (en) | 2013-10-16 | 2013-10-16 | Antibacterial composition and surface antibacterial treatment method using the same |
| Country | Link |
|---|---|
| KR (1) | KR101565012B1 (en) |
| WO (1) | WO2015056984A1 (en) |
| Publication number | Priority date | Publication date | Assignee | Title |
|---|---|---|---|---|
| CN110343637B (en)* | 2019-06-28 | 2021-06-08 | 浙江工业大学 | Enterobacter HY1 and its application in the degradation of bishydroxyethyl terephthalate |
| CN111972403A (en)* | 2020-09-11 | 2020-11-24 | 华南农业大学 | Method for preventing mildew of dried orange peel |
| CN118834520B (en)* | 2024-08-06 | 2025-02-11 | 东莞市万塑成塑料有限公司 | A high-elastic antibacterial PETG material, preparation method and medical packaging material |
| Publication number | Priority date | Publication date | Assignee | Title |
|---|---|---|---|---|
| US5910854A (en)* | 1993-02-26 | 1999-06-08 | Donnelly Corporation | Electrochromic polymeric solid films, manufacturing electrochromic devices using such solid films, and processes for making such solid films and devices |
| Title |
|---|
| Revue Roumaine de Chimie, 53(1), pp. 21-24(2008)* |
| RSC Advances, 3, pp. 2509-2519(2012.11.08.)* |
| 논문 : BIOMATERIALS |
| Publication number | Publication date |
|---|---|
| KR20150044256A (en) | 2015-04-24 |
| WO2015056984A1 (en) | 2015-04-23 |
| Publication | Publication Date | Title |
|---|---|---|
| Bandyopadhyay et al. | Anti-fouling chemistry of chiral monolayers: enhancing biofilm resistance on racemic surface | |
| EP3146842B1 (en) | Method for imparting an article or a hygiene product with antimicrobial activity and the article and the hygiene product imparted with the antimicrobial activity | |
| KR101565012B1 (en) | Antibacterial composition and surface antibacterial treatment method using the same | |
| JP2010529276A (en) | Antibacterial polymer nanocomposite | |
| KR20140118294A (en) | Graphene-based antibacterial composite and method for production thereof | |
| CN106538583A (en) | Long-acting disinfection bactericidal composition, its coating process and the renovation process for coating | |
| Zovko et al. | Antifungal and antibacterial activity of 3-alkylpyridinium polymeric analogs of marine toxins | |
| Ashiuchi et al. | Development of antimicrobial thermoplastic material from archaeal poly-γ-L-glutamate and its nanofabrication | |
| US20180127598A1 (en) | Uv cured benzophenone terminated quaternary ammonium antimicrobials for surfaces | |
| Gurol et al. | Phthalocyanine functionalized poly (vinyl alcohol) s via CuAAC click chemistry and their antibacterial properties | |
| CN108884340A (en) | Monomers, polymers, and coating formulations comprising at least one N-halamine precursor, a cationic center, and a coating-integrating group | |
| Kim et al. | The preparation and characterization of urushiol powders (YPUOH) based on urushiol | |
| US20150299475A1 (en) | Uv cured benzophenone terminated quarternary ammonium antimicrobials for surfaces | |
| CN113057178A (en) | A kind of preparation method of chitosan Schiff base-tannic acid-copper composite antibacterial powder | |
| Birtane et al. | Antibacterial UV-photocured acrylic coatings containing quaternary ammonium salt | |
| Rogalsky et al. | Antimicrobial properties and thermal stability of polycarbonate modified with 1‐alkyl‐3‐methylimidazolium tetrafluoroborate ionic liquids | |
| EP3148332A1 (en) | Coating antimicrobic film compositions | |
| Li et al. | Synthesis of antibacterial polyether biguanide curing agent and its cured antibacterial epoxy resin | |
| JP2001040222A (en) | Antimicrobial polymer particle and its production | |
| KR101326525B1 (en) | Aqueous polyurethane clear coating composition possessing antibacterial properties | |
| JP7475765B2 (en) | Antibacterial polymeric composition | |
| EP3865530A1 (en) | Antibacterial polymer and preparation method therefor | |
| Almehmadi et al. | Zinc oxide doped arylidene based polyketones hybrid nanocomposites for enhanced biological activity | |
| Oh et al. | Synthesis and antibacterial activity of versatile substrate‐coated biocidal material via catechol chemistry | |
| CN113121841A (en) | Inorganic composite guanidine salt polymer antibacterial agent and preparation method thereof |
| Date | Code | Title | Description |
|---|---|---|---|
| A201 | Request for examination | ||
| PA0109 | Patent application | Patent event code:PA01091R01D Comment text:Patent Application Patent event date:20131016 | |
| PA0201 | Request for examination | ||
| E902 | Notification of reason for refusal | ||
| PE0902 | Notice of grounds for rejection | Comment text:Notification of reason for refusal Patent event date:20150409 Patent event code:PE09021S01D | |
| PG1501 | Laying open of application | ||
| E701 | Decision to grant or registration of patent right | ||
| PE0701 | Decision of registration | Patent event code:PE07011S01D Comment text:Decision to Grant Registration Patent event date:20151026 | |
| GRNT | Written decision to grant | ||
| PR0701 | Registration of establishment | Comment text:Registration of Establishment Patent event date:20151027 Patent event code:PR07011E01D | |
| PR1002 | Payment of registration fee | Payment date:20151028 End annual number:3 Start annual number:1 | |
| PG1601 | Publication of registration | ||
| FPAY | Annual fee payment | Payment date:20180816 Year of fee payment:4 | |
| PR1001 | Payment of annual fee | Payment date:20180816 Start annual number:4 End annual number:4 | |
| PR1001 | Payment of annual fee | Payment date:20200410 Start annual number:5 End annual number:5 | |
| PR1001 | Payment of annual fee | Payment date:20200903 Start annual number:6 End annual number:6 | |
| PR1001 | Payment of annual fee | Payment date:20220901 Start annual number:8 End annual number:8 | |
| PR1001 | Payment of annual fee | Payment date:20240904 Start annual number:10 End annual number:10 |